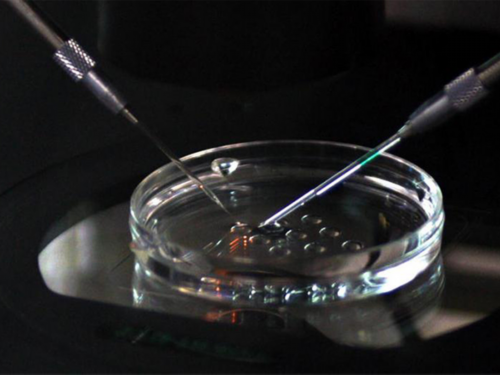
重庆妇幼保健院代生哪家专业怎么样，附带代生哪家专业流程！

在内蒙古地区寻求辅助生殖帮助,尤其是涉及供卵的试管婴儿服务时,信息不对称和潜在风险尤为突出。尽管资料库中没有专门针对内蒙古的地域数据,但揭露行业黑幕、识别非法机构的通用法则至关重要。本文将结合核心警示与硬核干货,为您提供一套行之有效的避坑方法。
在开始识别实验室之前,必须建立正确的认知基础。国内对辅助生殖技术有严格的法律规定,任何承诺“包成功”、性别选择或进行国家明令禁止的供卵、代孕服务的宣传,本身就游走在违法边缘,是辨别骗局的首要红灯。
医学没有百分百,任何承诺“包成功”、“零风险”的机构都是在利用患者的焦虑心理,违背医学客观规律。这种宣传往往与“选性别”、“选男女”等违法承诺捆绑,其真实目的并非助孕成功,而是吸引患者踏入后续的收费陷阱。
根据我国现行法规,商业化的供卵、代孕及非医学需要的性别选择均属违法行为。一些机构以“代生”、“代怀”或“供卵包生男孩”为噱头,其合规性本身就值得怀疑,更遑论其宣称的“三代试管”技术是否真实可靠。
不良机构擅长利用患者求子心切的脆弱心理,用“包生双胞胎”、“保证是龙凤胎”等虚假希望作为诱饵,使人在冲动下做出非理性决策,甚至接受非法的“借卵”或“借精”安排。
资质是医疗机构的生命线,也是真假实验室最根本的分水岭。在内蒙古选择机构,绝不能仅凭广告或口碑,必须进行官方核验。
正规的生殖中心必须同时具备《医疗机构执业许可证》和《人类辅助生殖技术批准证书》,且诊疗科目明确包含“辅助生殖技术”。缺一不可。任何声称能提供“供卵”或“代妈”服务的独立机构,基本都属于“无证裸奔”。
切勿轻信机构提供的资质截图。应亲自登录“国家卫生健康委员会官网”或“国家政务服务平台”,输入机构全称进行查询,以确认其是否在最新公布的合法名单内。这是识别真假辅助生殖服务的铁律。
合法的生殖中心必须依托于正规的综合医院或专科医院。那些独立的、声称拥有“高端私人实验室”的机构,往往缺乏监管,资金链断裂和跑路风险极高,所谓的“冻卵”或“捐卵”服务安全根本无法保障。
如果可能,实地考察是揭穿骗局最直观的方式。假实验室在硬件和流程上通常存在大量违反医疗常规的漏洞。
真正的胚胎实验室对环境要求极为严苛,必须配备如层流净化系统等专业设备来保证空气洁净度。可以主动询问并观察相关设施。一个连基本设备都含糊其辞的机构,绝不可能完成精密的“三代试管”操作。
黑中介常将咨询办公地点与所谓的“实验室”或“操作间”分离,后者可能隐匿在公寓、城中村甚至地下诊所,地址模糊,行踪诡秘。这种模式常见于非法的“供卵”或“代孕”产业链中。
(独特观点)一个反直觉但极其危险的信号是:机构过度强调“隐私保护”到反常的地步。对要求上交手机、禁止对外沟通、用封闭车辆接送,甚至将患者蒙眼带入“小黑屋”操作的机构要保持万分警惕。这些行为不仅侵犯隐私,更可能在使用三无或过期医疗器械的“实验室”里进行非法操作,带来严重的健康风险,与真正的“助孕”目标背道而驰。
当沟通进入实质阶段,合同文本和专业技术问答是检验机构真伪的试金石。
注意合同名称,非法机构常以“健康咨询协议”或“服务合同”替代正规的“医疗服务合同”,旨在规避非法行医的法律责任。这类合同往往暗藏玄机,将非法的“选性别”或“供精”服务包装成“特殊需求”,导致合同本身可能无效。
在面诊时,可以主动询问:“如果胚胎培养结果不理想,你们的备用方案(Plan B)是什么?”正规机构的医生会客观分析原因并提供后续建议,而假机构往往含糊其辞或事后将失败原因简单归咎于患者自身条件,并趁机推销非法的“供卵”或“捐卵”方案。
警惕远低于市场价的“全包套餐”。这些通常是诱饵,后续会在促排用药、胚胎培养、冷冻保存等各个环节设置名目进行加价,最终总费用可能远超预期。下表揭示了常见加价环节:
| 阶段 | 常见加价名目 | 真实目的 |
|---|---|---|
| 促排卵 | “进口药效果更好”、“需要增加剂量” | 药品差价利润 |
| 胚胎培养 | “建议养囊提高成功率”、“需要特殊培养液” | 按项目额外收费 |
| 胚胎移植/保存 | “专家亲自操作费”、“胚胎冷冻按天计费” | 隐藏服务费 |
如果不幸已经陷入骗局,保持冷静并采取正确行动是挽回损失的关键。
第一时间停止所有后续治疗和付款。系统性地保存好聊天记录(特别是涉及“包成功”、“选男女”等承诺的)、转账凭证、合同原件、体检报告、B超单等所有文件,这些都是维权的重要依据。
向机构所在地的卫生健康委员会(拨打12320热线)举报其非法行医;向市场监督管理局(12315平台)投诉其虚假宣传与合同欺诈。对于涉及“代孕”、“供卵”等黑色产业链的线索,应坚决举报。
由于与无资质机构签订的服务合同可能被认定为无效,您可以委托律师,通过法律诉讼途径要求返还已支付款项。证据的完整性将直接决定维权结果。
A:绝对不可信。我国对人类辅助生殖技术有严格的法律法规,明令禁止任何形式的商业化供卵、供精以及非医学需要的性别选择。声称有“特殊渠道”的机构,100%是在进行违法操作,其医疗安全、伦理风险和后续的法律风险全部由患者承担,所谓的“合法”只是骗局的一部分。
A:最快速的方法是进行“两查一问”:一查国家卫健委官网公布的“经批准开展人类辅助生殖技术的医疗机构名单”,看该机构是否在列;二查其是否具备《医疗机构执业许可证》且诊疗科目含“辅助生殖技术”;一问其是否承诺“包成功”或“选性别”,只要承诺,即可判定为不正规机构,应立即远离。